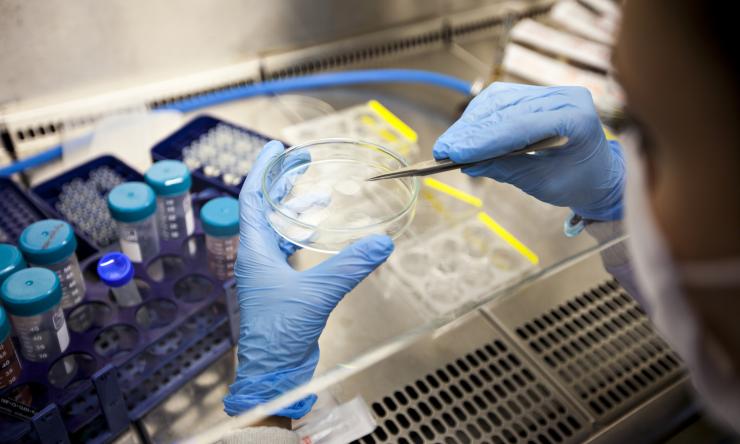
Generic lab image

Triggering antiviral immune response in certain breast cancers
Researchers at Baylor College of Medicine have discovered how therapeutics targeting RNA splicing can activate antiviral immune pathways in triple negative breast cancers (TNBC) to trigger tumor cell death and signal the body’s immune response. A new study published in Cell shows that endogenous mis-spliced RNA in tumor cells mimics an RNA virus, leading tumor cells to self-destruct as if fighting an infection. Researchers suggest this mechanism could open new avenues for turning on the immune system in aggressive cancers like TNBC.
“We know therapeutics that partially interfere with RNA splicing can have a very strong impact on tumor growth and progression, but the mechanisms of tumor killing are largely unknown. In this study, we discovered that these therapeutics are modulators of anti-tumor immunity,” said Dr. Trey Westbrook, corresponding author of the study, executive director of the Therapeutic Innovation Center (THINC) and McNair Scholar in Cancer Research at Baylor.
RNA splicing—the removal of non-coding introns—is often deregulated in tumors, leading to tumor growth but also making the tumor hypersensitive to spliceosome-targeted therapies (STTs). Triple negative breast cancer is one of many aggressive cancers that are responsive to STTs.
Westbrook’s team wanted to understand how those drugs interfere with tumor progression. They found that in TNBC cells, STTs interfere with RNA splicing and cause a buildup of endogenous mis-spliced intron RNA in the tumor cell cytoplasm. Many of those aberrant RNAs will form double-stranded structures, just like an RNA virus. Antiviral immune pathways recognize the double-stranded RNA and then trigger apoptosis and send signals to the body’s immune system to illicit an inflammatory response.
“Our study highlights an unanticipated way to activate an inflammatory response through specifically targeting cancer cells. These findings emphasize that when we think about the activity of cancer therapeutics, we need to look both at how they impact cancer cells as well as the effect this might have on the immune system,” said Dr. Elizabeth Bowling, co-first author and member of the Westbrook lab.
“We now have a clearer understanding of how high levels of mis-splicing results in cellular stress in breast cancer. Furthermore, we suspect this RNA splicing stress may be present in many cancer types and disease states,” said Dr. Jarey Wang, co-first author, member of the Westbrook lab and graduate of the Baylor Medical Scientist Training Program.
These discoveries may also lead to new biomarkers to select patients that respond to current immune-modulating therapies. Specifically, the research suggests that a tumor cell’s endogenous mis-spliced RNA may be able to stimulate the immune system even without therapeutic (STT) treatment. The data shows a correlation between mis-spliced RNA and immune signatures, even in tumors that are typically immune-cold. The study authors hypothesize that this endogenous mis-spliced RNA could be used as a clinical biomarker to find which cancers will be sensitive to immunotherapy. The researchers say further study is needed to determine if STTs activation of anti-tumor immune pathways could make more patients eligible for immunotherapy.
“While immunotherapy is having profound effects for some cancer patients, it still only works in a minority of cancer patients. It’s imperative that we learn how to broaden the swath of patients who might benefit from immunotherapy. This discovery uncovers a new mechanism by which cancers are speaking to the immune system and gives us strategies to exploit that for the benefit of patients,” said Westbrook, Welch Chair in Chemistry, professor in the Verna and Marrs McLean Department of Biochemistry and Molecular Biology and Department of Molecular and Human Genetics and member of the Dan L Duncan Comprehensive Cancer Center at Baylor.
For a full list of authors and financial contributions, see the publication.